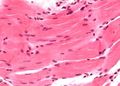
Миниатюра для версии от 11:30, 19 июля 2016

Спорт-вики — википедия научного бодибилдинга
Файл:Mishci sport65.jpg
Mishci_sport65.jpg (301 × 216 пикселей, размер файла: 11 КБ, MIME-тип: image/jpeg)
Гистологическое строение гладких мышц — гладкомышечные веретенообразные клетки с одиночным расположенным в центре ядром; миофибриллы не видны
История файла
Нажмите на дату/время, чтобы просмотреть, как тогда выглядел файл.
| Дата/время | Миниатюра | Размеры | Участник | Примечание | |
|---|---|---|---|---|---|
| текущий | 11:30, 19 июля 2016 | | 301 × 216 (11 КБ) | Anes (обсуждение | вклад) | Гистологическое строение гладких мышц — гладкомышечные веретенообразные клетки с одиночным расположенным в центре ядром; миофибриллы… |
- Вы не можете перезаписать этот файл.
Использование файла
Следующая 1 страница ссылается на данный файл:

